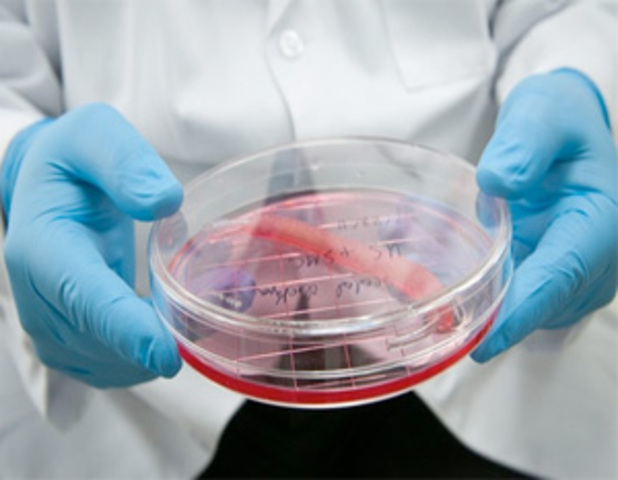
Cultivo

-
Teoría del germen de la enfermedad
-
Descubrimiento del ciclo de vida del parásito de la Malaria
-
Los ratones y la genética
-
Primera cirugía de trasplante en seres humanos
-
Prevención de la difteria por inmunización
-
Descubrimiento de la vitamina A
-
Transfusión de sangre
-
Demostración de la neurotransmisión
-
Aislamiento de la insulina
-
Anemia perniciosa
-
Heparina utilizada como anticoagulante
-
La penicilina protege a los ratones frente a las infecciones
-
Desarrollo de la diálisis para la insuficiencia renal
-
Desarrollo de la vacuna contra la polio
-
Marcapasos cardíacos
-
Válvulas cardíacas artificiales
-
Trasplantes de corazón con éxito en seres humanos
-
Erradicación de la viruela a través de la vacunación
-
Desarrollo de tratamientos para la lepra
-
AZT - el primer fármaco para el tratamiento del VIH
-
Vacuna para la meningitis por Hib
-
La clonación de la oveja Dolly
-
Secuenciación y análisis del genoma de ratón
-
Primer trasplante de un órgano completo cultivado
Plan projects on a visual timeline
Map milestones, phases, deadlines, and key events in one place so the sequence is easier to see and share. Timetoast is a timeline maker for work, school, research, and stories.